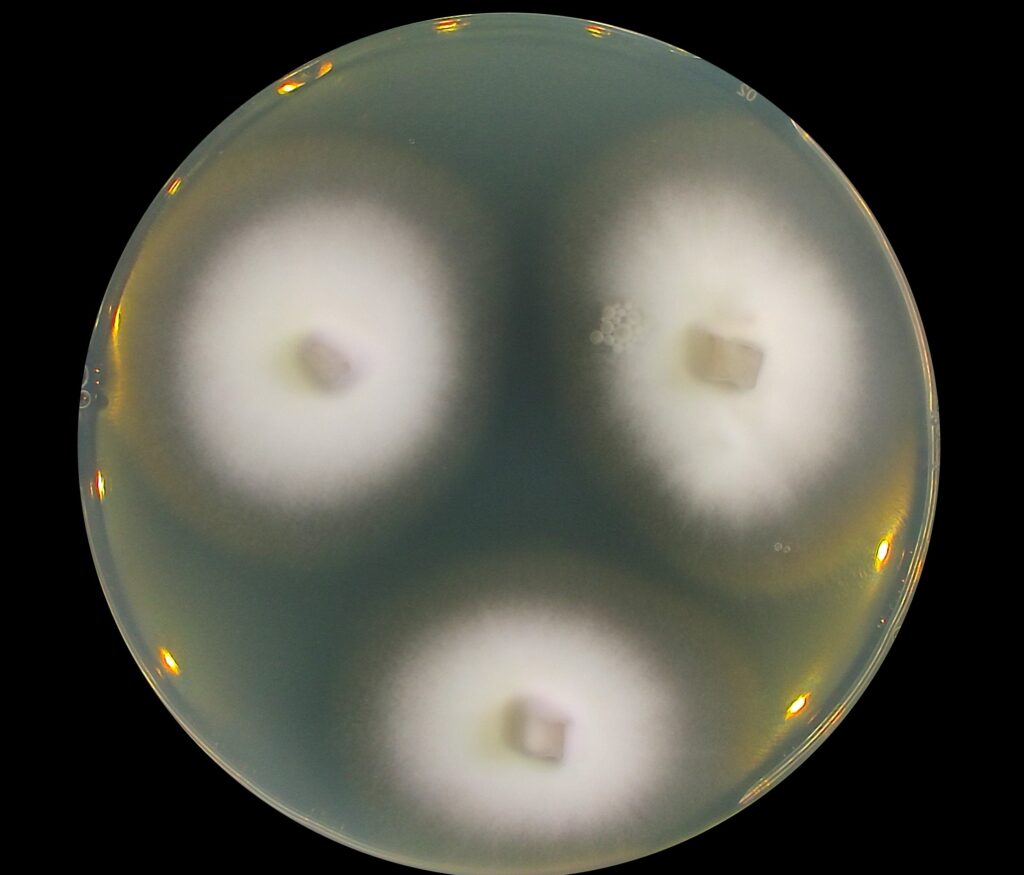

Vyrážka dokáže člověka rychle omezit. Svědí. Pálí. Může se šířit na místa, kde se kůže potí. Někdy ji způsobují i kožní plísně, například v meziprstí nebo v tříslech. V české prostředí většinou reaguje na běžné masti. Představte si ale situaci, kdy se rozšiřuje dál a nic na ni nezabírá. Takové potíže se objevují u infekcí způsobených houbou Trichophyton mentagrophytes var. indotineae. Tato houba dokáže zasáhnout trup, končetiny, vlasatou část hlavy i intimní místa. Šíří se kontaktem s kůží nebo přes kontaminované předměty. Způsobuje svědění a narušuje spánek. Výrazně snižuje kvalitu života. Právě tento druh nyní podrobně zkoumali vědci z Mikrobiologického ústavu AV ČR.
V Íránu se tato houba vyskytuje ve vysoké frekvenci a vykazuje zvýšenou odolnost vůči běžným antimykotikům. „Naše práce slouží jako pre invasion assessment. To znamená předběžné posouzení rizika, zda by se tato houba mohla šířit i do Evropy,“ říká vedoucí výzkumného týmu Adéla Wennrich z Mikrobiologického ústavu AV ČR (MBÚ AV ČR). „Sledujeme situaci tam, kde se problém objevuje dříve. Díky tomu víme, co může přijít a jak na to rychle reagovat. Výsledky nám pomáhají tyto houby spolehlivě poznat a léčit.“
Druhým hlavním partnerem byl Ali Rezaei Matehkolaei z Lékařské univerzity Džundišápúr v Ahvazu. Klinické vzorky pocházely z devíti provincií napříč Íránem. Vyšetřeno bylo 2211 lidí s příznaky kožního onemocnění a vědci z nich kultivovali celkem 1538 vzorků patogenních hub. Nejčastěji se objevoval druh Trichophyton mentagrophytes var. indotineae, dříve okrajový patogen, který nyní způsoboval více než tři čtvrtiny všech infekcí. Analýzy probíhaly v Íránu i v České republice. Podmínky pro výzkum jsou v Íránu náročné. Vědci tam často pracují s omezenými zdroji a nestabilním zázemím. Proto je důležitá mezinárodní podpora a spolupráce. Bez ní by studie takového rozsahu nevznikla.
Studie potvrdila vysoký podíl vzorků odolných vůči léčbě. V Íránu se tento patogen vyskytuje s vysokou diverzitou. To znamená, že v této oblastiexistuje velká rozmanitost hub stejného druhu a je možné, že právě v tomto prostředí vznikají nové genotypy. Ty mohou mít jiné vlastnosti, například lepší schopnost šířit se mezi lidmi nebo vyšší odolnost vůči léčbě. V našem výzkumu jsme popsali i nový genotyp této houby. Tento genotyp nese mutace v genu pro skvalenepoxidázu, které způsobují rezistenci některých kmenů k používaným antimykotikům. Tento nový genotyp je zatím hlášený pouze z Íránu. Další genotypy, které jsou také odolné k léčbě, se však už šíří světem a byly detekované i v Evropě.
„Výzkum ukazuje význam mezinárodní spolupráce. Jen tak můžeme včas zachytit změny u hub, které mohou ovlivnit veřejné zdraví,“ dodává Miroslav Kolařík z MBÚ AV ČR.
Výsledky studie ukazují, že sledování diverzity tohoto patogenu v oblastech jeho intenzivního výskytu je zásadní pro pochopení jeho vývoje. Včasné rozpoznání rezistentních kmenů umožňuje upravit léčbu a zlepšit péči o pacienty. Studie tak poskytuje Evropě důležitý náskok v přípravě na infekce, které se mohou v budoucnu šířit i v našem regionu.
Kontakt pro média:
Kateřina Voráčová, PR ústavu: , 778 421 375
PUBLIKACE
Takesh A, Wennrich A, Kolařík M, Zarei-Mahmoudabadi A, Kiasat N, Pazyar N, Rafiei A, Abastabar M, Haghani I, Kharazi M, Basiri S, Jahanshiri Z, Khodadadi H, Mohammadi R, Zarrinfar H, Seifi Z, Diba K, Kamali Sarvestani H, Rezaei-Matehkolaei A (2026) Dermatophytosis in Iran: a sharp increase in cases caused by Trichophyton mentagrophytes var. indotineae. IMA Fungus 17: e180817. https://doi.org/10.3897/imafungus.17.180817
T. indotineae houba rostoucí na agarové plotně (Mikrobiologický ústav AV ČR)


